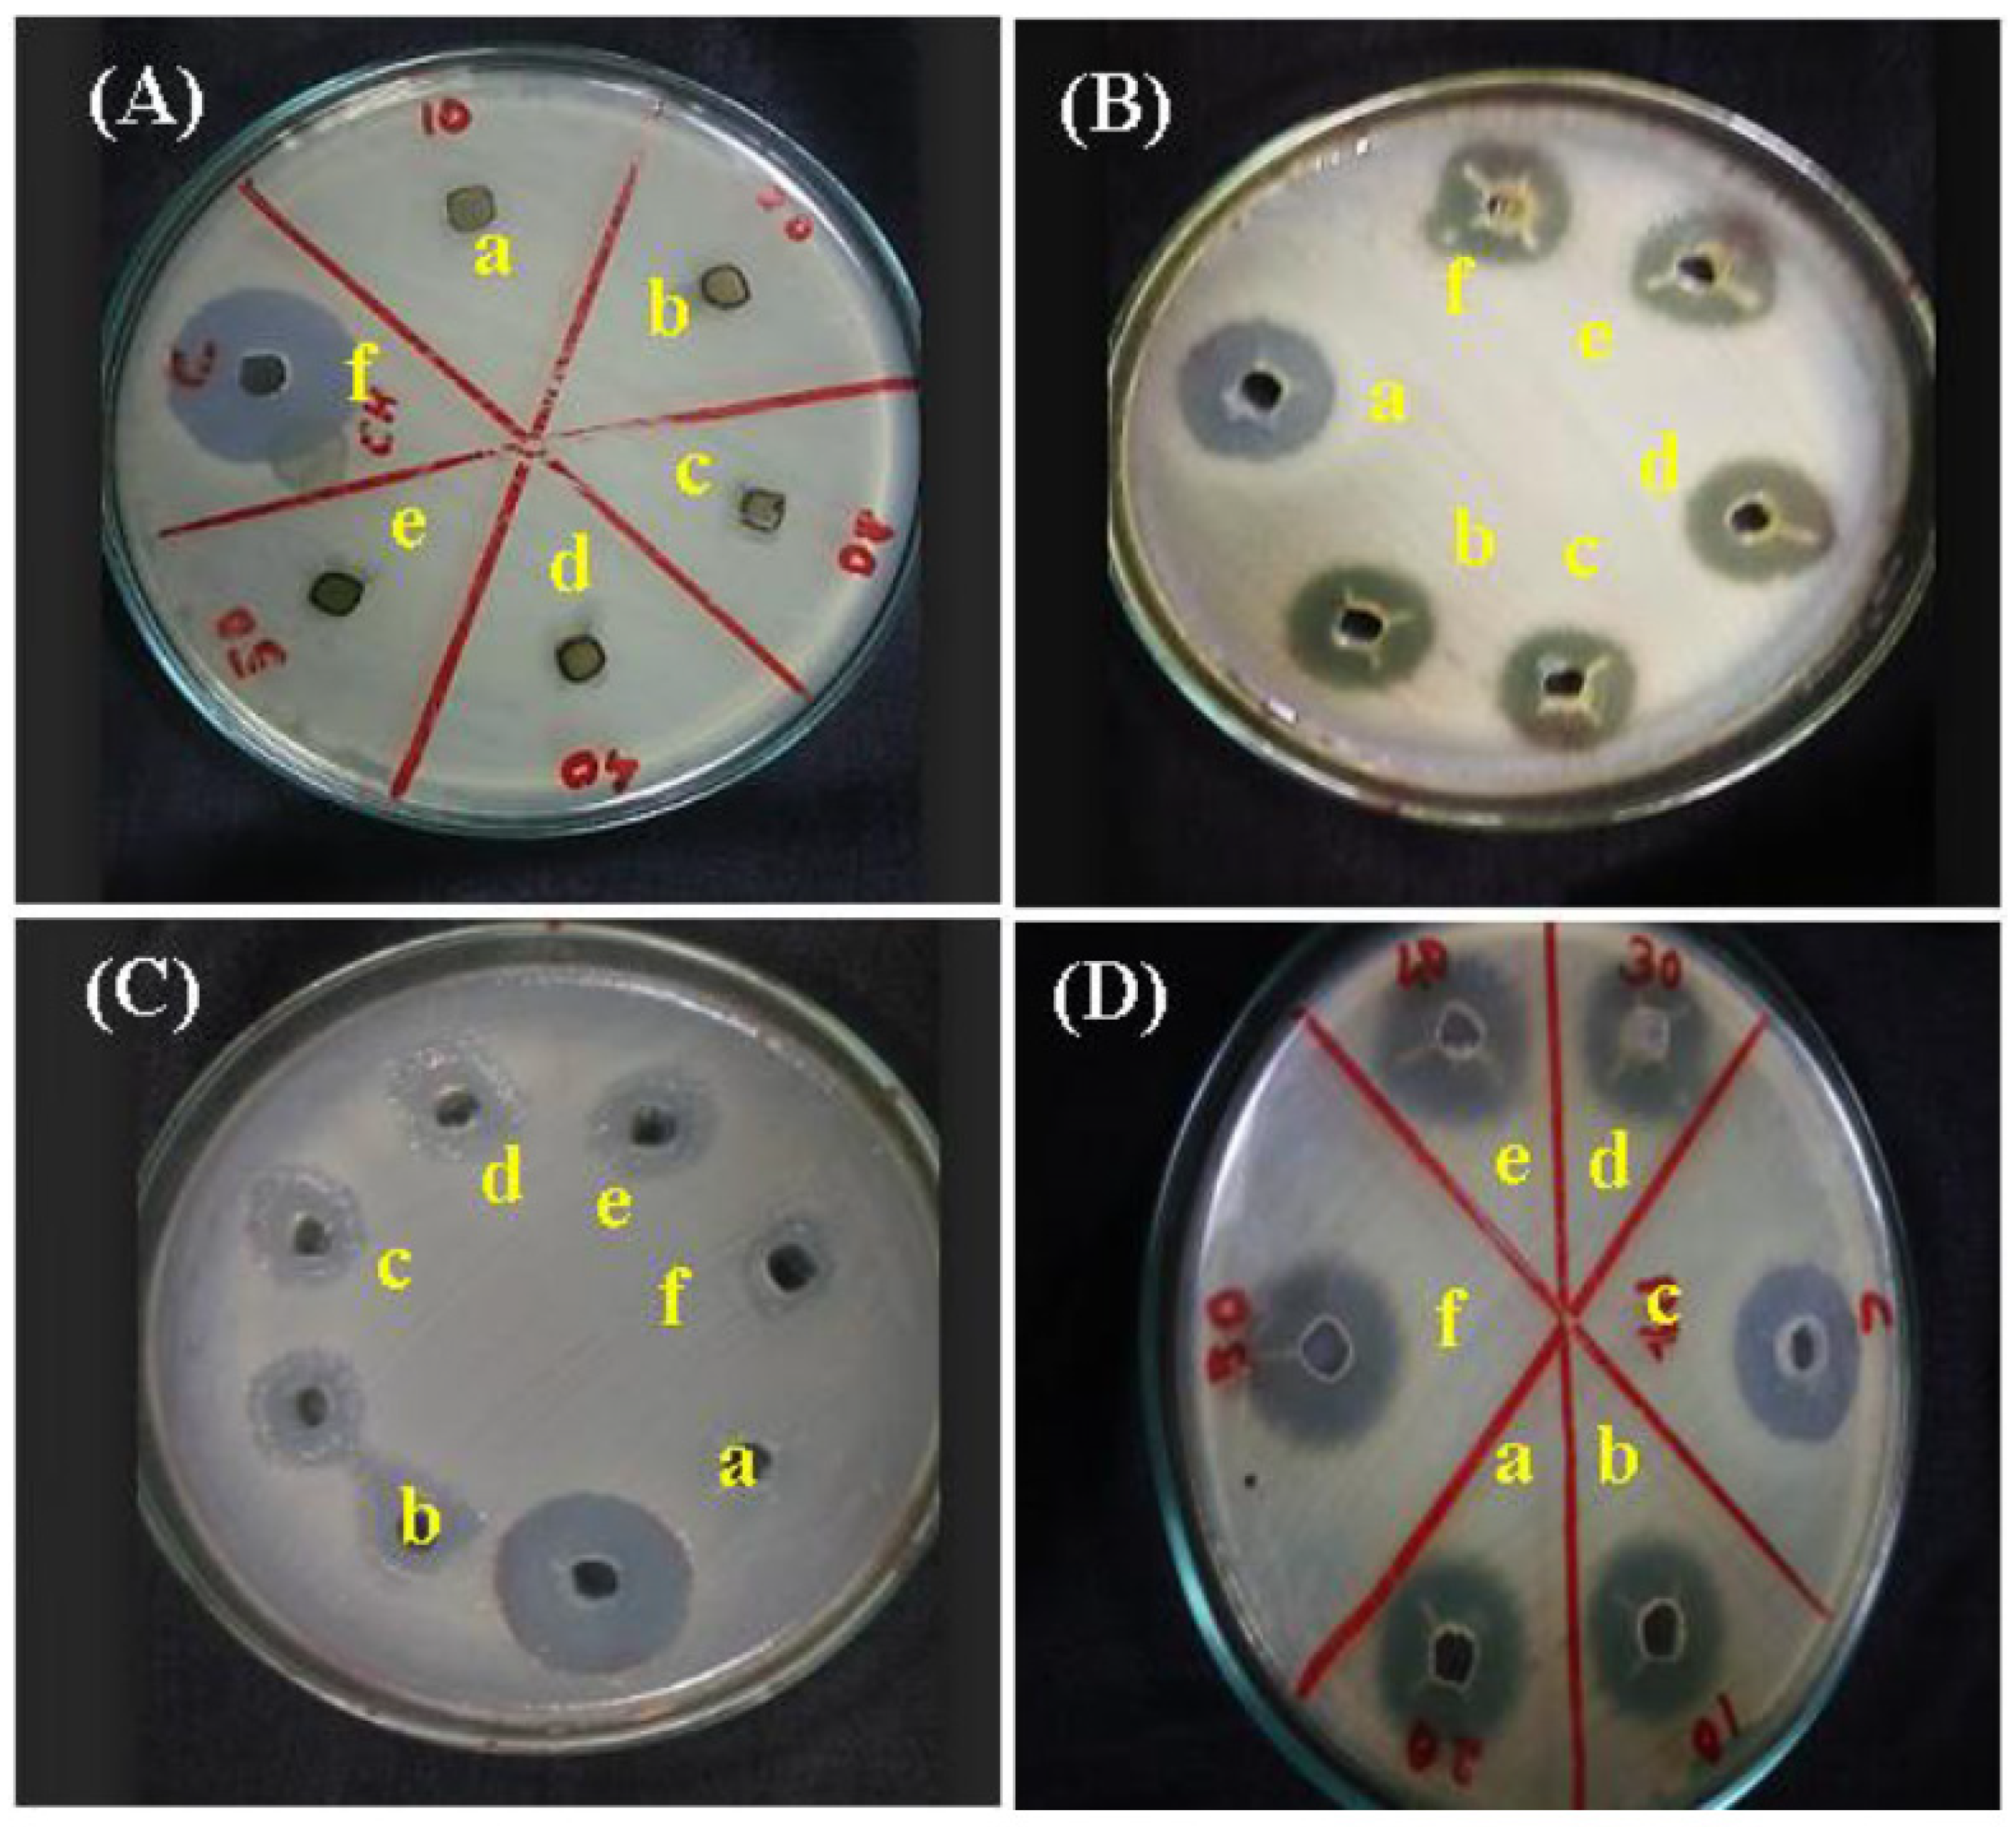
Gels 09 00539 g015 Gels 09 00539 g015

Aloe vera-Based Hydrogels for Wound Healing: Properties and Therapeutic Effects
Abstract
1. Introduction
2. Phytochemical Constituents of Aloe vera
3. Preparation of Aloe vera Hydrogels
4. Biological and Pharmacological Effects of Aloe vera
4.1. Reduction of Inflammation
4.2. Prevention of Bacterial Infection
4.3. Skin Regeneration
4.4. Healing Burns
4.5. Protection against Chemoradiation Secondary Effects in Cancer Treatment
4.6. Summary of Clinical Effects of AV on Prevention and Healing of Skin Wounds
5. Side Effects
6. Conclusions and Future Prospective Studies
Author Contributions
Funding
Institutional Review Board Statement
Informed Consent Statement
Data Availability Statement
Conflicts of Interest
References
- Ekor, M. The growing use of herbal medicines: Issues relating to adverse reactions and challenges in monitoring safety. Front. Pharmacol. 2014, 10, 177. [Google Scholar] [CrossRef] [PubMed]
- Khan, M.S.A.; Ahmad, I. Chapter 1-Herbal Medicine: Current Trends and Future Prospects; New Look to Phytomedicine; Khan, M.S.A., Ahmad, I., Chattopadhyay, D., Eds.; Academic Press: Cambridge, MA, USA, 2019; pp. 3–13. ISBN 9780128146194. [Google Scholar] [CrossRef]
- Surjushe, A.; Vasani, R.; Saple, D.G. Aloe vera: A short review. Indian J. Dermatol. 2008, 53, 163–166. [Google Scholar] [CrossRef] [PubMed]
- Kumar, R.; Singh, A.K.; Gupta, A.; Bishayee, A.; Pandey, A.K. Therapeutic potential of Aloe vera—A miracle gift of nature. Phytomedicine 2019, 60, 152996. [Google Scholar] [CrossRef] [PubMed]
- Manvitha, K.; Bidya, B. Aloe vera: A wonder plant its history, cultivation and medicinal uses. J. Pharm. Phytochem. 2014, 2, 85–88. [Google Scholar]
- Mehta, D.I. “History OF Aloe vera” – (A Magical Plant). IOSR J. Humanit. Soc. Sci. 2017, 22, 21–24. [Google Scholar]
- Gao, Y.; Kuok, K.I.; Jin, Y.; Wang, R. Biomedical applications of Aloe vera. Crit. Rev. Food Sci. Nutr. 2019, 59, S244–S256. [Google Scholar] [CrossRef]
- Available online: https://www.fortunebusinessinsights.com/aloe-vera-extract-market-103893 (accessed on 20 May 2023).
- Deep, A.; Kumar, D.; Bansal, N.; Narasimhan, B.; Marwaha, R.K.; Sharma, P.C. Understanding mechanistic aspects and therapeutic potential of natural substances as anticancer agents. Phytomed. Plus 2023, 3, 100418. [Google Scholar] [CrossRef]
- Noori, A.S.; Mageed, N.F.; Abdalameer, N.K.; Mohammed, M.K.; Mazhir, S.N.; Ali, A.H.; Jaber, N.A.; Mohammed, S.H. The histological effect of activated Aloe vera extract by microwave plasma on wound healing. Chem. Phys. Lett. 2022, 807, 140112. [Google Scholar] [CrossRef]
- Kim, S.-T.; Pressman, P.; Clemens, R.; Moore, A.; Hamilton, R.; Hayes, A.W. The absence of genotoxicity of Aloe vera beverages: A review of the literature. Food Chem. Toxicol. 2023, 174, 113628. [Google Scholar] [CrossRef]
- Sánchez-Machado, D.I.; López-Cervantes, J.; Sendón, R.; Sanches-Silva, A. Aloe vera: Ancient knowledge with new frontiers. Trends Food Sci. Technol. 2017, 61, 94–102. [Google Scholar] [CrossRef]
- Altinkaynak, C.; Haciosmanoglu, E.; Ekremoglu, M.; Hacioglu, M.; Özdemir, N. Anti-microbial, anti-oxidant and wound healing capabilities of Aloe vera-incorporated hybrid nanoflowers. J. Biosci. Bioeng. 2023, 135, 321–330. [Google Scholar] [CrossRef] [PubMed]
- Hattingh, A.; Laux, J.-P.; Willers, C.; Hamman, J.; Steyn, D.; Hamman, H. In vitro wound healing effects of combinations of Aloe vera gel with different extracts of Bulbine frutescens. S. Afr. J. Bot. 2023, 158, 254–264. [Google Scholar] [CrossRef]
- Movaffagh, J.; Khatib, M.; Bazzaz, B.S.F.; Taherzadeh, Z.; Hashemi, M.; Moghaddam, A.S.; Tabatabaee, S.A.; Azizzadeh, M.; Jirofti, N. Evaluation of wound-healing efficiency of a functional Chitosan/Aloe vera hydrogel on the improvement of re-epithelialization in full thickness wound model of rat. J. Tissue Viabil. 2022, 31, 649–656. [Google Scholar] [CrossRef] [PubMed]
- Abdel-Mohsen, A.M.; Frankova, J.; Abdel-Rahman, R.M.; Salem, A.A.; Sahffie, N.M.; Kubena, I.; Jancar, J. Chitosan-glucan complex hollow fibers reinforced collagen wound dressing embedded with Aloe vera. II. Multifunctional properties to promote cutaneous wound healing. Int. J. Pharm. 2020, 582, 119349. [Google Scholar] [CrossRef] [PubMed]
- Ghorbani, M.; Nezhad-Mokhtari, P.; Ramazani, S. Aloe vera-loaded nanofibrous scaffold based on Zein/Polycaprolactone/Collagen for wound healing. Int. J. Biol. Macromol. 2020, 153, 921–930. [Google Scholar] [CrossRef]
- Farid, A.; Haridyy, H.; Ashraf, S.; Ahmed, S.; Safwat, G. Aloe vera gel as a stimulant for mesenchymal stem cells differentiation and a natural therapy for radiation induced liver damage. J. Radiat. Res. Appl. Sci. 2022, 15, 270–278. [Google Scholar] [CrossRef]
- Razia, S.; Park, H.; Shin, E.; Shim, K.-S.; Cho, E.; Kang, M.C.; Kim, S.Y. Synergistic effect of Aloe vera flower and Aloe gel on cutaneous wound healing targeting MFAP4 and its associated signaling pathway: In-vitro study. J. Ethnopharmacol. 2022, 290, 115096. [Google Scholar] [CrossRef]
- Sharifi, E.; Chehelgerdi, M.; Fatahian-Kelishadrokhi, A.; Yazdani-Nafchi, F.; Ashrafi-Dehkordi, K. Comparison of therapeutic effects of encapsulated Mesenchymal stem cells in Aloe vera gel and Chitosan-based gel in healing of grade-II burn injuries. Regen. Ther. 2021, 21, 30–37. [Google Scholar] [CrossRef]
- Hekmatpou, D.; Mehrabi, F.; Rahzani, K.; Aminiyan, A. The Effect of Aloe vera Clinical Trials on Prevention and Healing of Skin Wound: A Systematic Review. Iran J. Med. Sci. 2019, 44, 1–9. [Google Scholar] [CrossRef]
- Tejiram, S.; Kavalukas, S.L.; Shupp, J.W.; Barbul, A. 1-Wound healing. In Ågren, Wound Healing Biomaterials; Magnus, S., Ed.; Woodhead Publishing: Sawston, UK, 2016; pp. 3–39. [Google Scholar] [CrossRef]
- Clark, R.A.F.; Musillo, M.; Stransky, T. Chapter 70—Wound repair: Basic biology to tissue engineering. In Principles of Tissue Engineering, 5th ed.; Lanza, R., Langer, R., Vacanti, J.P., Atala, A., Eds.; Academic Press: Cambridge, MA, USA, 2020; pp. 1309–1329. [Google Scholar] [CrossRef]
- Frykberg, R.G.; Banks, J.; Deptuła, M.; Karpowicz, P.; Wardowska, A.; Sass, P.; Sosnowski, P.; Mieczkowska, A.; Filipowicz, N.; Dzierżyńska, M.; et al. Challenges in the Treatment of Chronic Wounds. Adv. Wound Care 2015, 4, 560–582. [Google Scholar] [CrossRef]
- Nguyen, H.M.; Le, T.T.N.; Nguyen, A.T.; Le, H.N.T.; Pham, T.T. Biomedical materials for wound dressing: Recent advances and applications. RSC Adv. 2023, 13, 5509–5528. [Google Scholar] [CrossRef]
- Yaşayan, G.; Nejati, O.; Ceylan, A.F.; Karasu, C.; Ugur, P.K.; Bal-Öztürk, A.; Zarepour, A.; Zarrabi, A.; Mostafavi, E. Tackling chronic wound healing using nanomaterials: Advancements, challenges, and future perspectives. Appl. Mater. Today 2023, 32, 101829. [Google Scholar] [CrossRef]
- Verdes, M.; Mace, K.; Margetts, L.; Cartmell, S. Status and challenges of electrical stimulation use in chronic wound healing. Curr. Opin. Biotechnol. 2022, 75, 102710. [Google Scholar] [CrossRef] [PubMed]
- Bormann, D.; Gugerell, A.; Ankersmit, H.J.; Mildner, M. Therapeutic Application of Cell Secretomes in Cutaneous Wound Healing. J. Investig. Dermatol. 2023, 143, 893–912. [Google Scholar] [CrossRef] [PubMed]
- Middelkoop, E.; Sheridan, R.L. Skin Substitutes and ‘the next level’. In Total Burn Care; Elsevier: Amsterdam, The Netherlands, 2018; pp. 167–173.e2. [Google Scholar] [CrossRef]
- Shi, C.; Wang, C.; Liu, H.; Li, Q.; Li, R.; Zhang, Y.; Liu, Y.; Shao, Y.; Wang, J. Selection of Appropriate Wound Dressing for Various Wounds. Front. Bioeng. Biotechnol. 2020, 8, 182. [Google Scholar] [CrossRef]
- Alven, S.; Khwaza, V.; Oyedeji, O.O.; Aderibigbe, B.A. Polymer-Based Scaffolds Loaded with Aloe vera Extract for the Treatment of Wounds. Pharmaceutics 2021, 13, 961. [Google Scholar] [CrossRef] [PubMed]
- Hasan, S.; Hasan, M.A.; Hassan, M.U.; Amin, M.; Javed, T.; Fatima, L. Biopolymers in diabetic wound care management: A potential substitute to traditional dressings. Eur. Polym. J. 2023, 189, 111979. [Google Scholar] [CrossRef]
- Corrales-Orovio, R.; Carvajal, F.; Holmes, C.; Miranda, M.; González-Itier, S.; Cárdenas, C.; Vera, C.; Schenck, T.L.; Egaña, J.T. Development of a photosynthetic hydrogel as potential wound dressing for the local delivery of oxygen and bioactive molecules. Acta Biomater. 2023, 155, 154–166. [Google Scholar] [CrossRef]
- Smith, R.; Russo, J.; Fiegel, J.; Brogden, N. Antibiotic Delivery Strategies to Treat Skin Infections When Innate Antimicrobial Defense Fails. Antibiotics 2020, 9, 56. [Google Scholar] [CrossRef]
- Popova, T.P.; Ignatov, I.; Petrova, T.E.; Kaleva, M.D.; Huether, F.; Karadzhov, S.D. Antimicrobial Activity In Vitro of Cream from Plant Extracts and Nanosilver, and Clinical Research In Vivo on Veterinary Clinical Cases. Cosmetics 2022, 9, 122. [Google Scholar] [CrossRef]
- Moretta, A.; Scieuzo, C.; Petrone, A.M.; Salvia, R.; Manniello, M.D.; Franco, A.; Lucchetti, D.; Vassallo, A.; Vogel, H.; Sgambato, A.; et al. Antimicrobial Peptides: A New Hope in Biomedical and Pharmaceutical Fields. Front. Cell. Infect. Microbiol. 2021, 11, 668632. [Google Scholar] [CrossRef]
- Ghasemi, A.H.; Farazin, A.; Mohammadimehr, M.; Naeimi, H. Fabrication and characterization of biopolymers with antibacterial nanoparticles and Calendula officinalis flower extract as an active ingredient for modern hydrogel wound dressings. Mater. Today Commun. 2022, 31, 103513. [Google Scholar] [CrossRef]
- Huda, R.M.; Rashdan, H.R.; El-Naggar, M.E. Chapter 2-Traditional and modern wound dressings. In Developments in Applied Microbiology and Biotechnology, Antimicrobial Dressings; Khan, R., Gowri, S., Eds.; Academic Press: Cambridge, MA, USA, 2023; pp. 21–42. [Google Scholar] [CrossRef]
- Ferroni, L.; Gardin, C.; D’Amora, U.; Calzà, L.; Ronca, A.; Tremoli, E.; Ambrosio, L.; Zavan, B. Exosomes of mesenchymal stem cells delivered from methacrylated hyaluronic acid patch improve the regenerative properties of endothelial and dermal cells. Biomater. Adv. 2022, 139, 213000. [Google Scholar] [CrossRef] [PubMed]
- Feketshane, Z.; Adeyemi, S.A.; Ubanako, P.; Ndinteh, D.T.; Ray, S.S.; Choonara, Y.E.; Aderibigbe, B.A. Dissolvable sodium alginate-based antibacterial wound dressing patches: Design, characterization, and in vitro biological studies. Int. J. Biol. Macromol. 2023, 232, 123460. [Google Scholar] [CrossRef] [PubMed]
- Fligge, M.; Letofsky-Papst, I.; Bäumers, M.; Zimmer, A.; Breitkreutz, J. Personalized dermal patches–Inkjet printing of prednisolone nanosuspensions for individualized treatment of skin diseases. Int. J. Pharm. 2023, 630, 122382. [Google Scholar] [CrossRef] [PubMed]
- Raepsaet, C.; Alves, P.; Cullen, B.; Gefen, A.; Lázaro-Martínez, J.L.; Lev-Tov, H.; Najafi, B.; Santamaria, N.; Sharpe, A.; Swanson, T.; et al. The development of a core outcome set for clinical effectiveness studies of bordered foam dressings in the treatment of complex wounds. J. Tissue Viability 2023. [Google Scholar] [CrossRef]
- Genesi, B.P.; de Melo Barbosa, R.; Severino, P.; Rodas, A.C.D.; Yoshida, C.M.P.; Mathor, M.B.; Lopes, P.S.; Viseras, C.; Souto, E.B.; da Silva, C.F. Aloe vera and copaiba oleoresin-loaded chitosan films for wound dressings: Microbial permeation, cytotoxicity, and in vivo proof of concept. Int. J. Pharm. 2023, 634, 122648. [Google Scholar] [CrossRef]
- Rajati, H.; Alvandi, H.; Rahmatabadi, S.S.; Hosseinzadeh, L.; Arkan, E. A nanofiber-hydrogel composite from green synthesized AgNPs embedded to PEBAX/PVA hydrogel and PA/Pistacia atlantica gum nanofiber for wound dressing. Int. J. Biol. Macromol. 2023, 226, 1426–1443. [Google Scholar] [CrossRef]
- Revete, A.; Aparicio, A.; Cisterna, B.A.; Revete, J.; Luis, L.; Ibarra, E.; González, E.A.S.; Molino, J.; Reginensi, D. Advancements in the Use of Hydrogels for Regenerative Medicine: Properties and Biomedical Applications. Int. J. Biomater. 2022, 2022, 3606765. [Google Scholar] [CrossRef]
- Caló, E.; Khutoryanskiy, V.V. Biomedical applications of hydrogels: A review of patents and commercial products. Eur. Polym. J. 2015, 65, 252–267. [Google Scholar] [CrossRef]
- Taaca, K.L.M.; Prieto, E.I.; Vasquez, M.R., Jr. Current Trends in Biomedical Hydrogels: From Traditional Crosslinking to Plasma-Assisted Synthesis. Polymers 2022, 14, 2560. [Google Scholar] [CrossRef] [PubMed]
- Bustamante-Torres, M.; Romero-Fierro, D.; Arcentales-Vera, B.; Palomino, K.; Magaña, H.; Bucio, E. Hydrogels Classification According to the Physical or Chemical Interactions and as Stimuli-Sensitive Materials. Gels 2021, 7, 182. [Google Scholar] [CrossRef] [PubMed]
- Palencia, M.; Lerma, T.A.; Garcés, V.; Mora, M.A.; Martínez, J.M.; Palencia, S.L. Chapter 9-Eco-friendly hydrogels. In Advances in Green and Sustainable Chemistry, Eco-Friendly Functional Polymers; Palencia, M., Lerma, T.A., Garcés, V., Mora, M.A., Martínez, J.M., Palencia, S.L., Eds.; Elsevier: Amsterdam, The Netherlands, 2021; pp. 141–153. [Google Scholar] [CrossRef]
- Firlar, I.; Altunbek, M.; McCarthy, C.; Ramalingam, M.; Camci-Unal, G. Functional Hydrogels for Treatment of Chronic Wounds. Gels 2022, 8, 127. [Google Scholar] [CrossRef] [PubMed]
- Ruffo, M.; Parisi, O.I.; Dattilo, M.; Patitucci, F.; Malivindi, R.; Pezzi, V.; Tzanov, T.; Puoci, F. Synthesis and evaluation of wound healing properties of hydro-diab hydrogel loaded with green-synthetized AGNPS: In vitro and in ex vivo studies. Drug Deliv. Transl. Res. 2022, 12, 1881–1894. [Google Scholar] [CrossRef]
- Solanki, D.; Vinchhi, P.; Patel, M.M. Design Considerations, Formulation Approaches, and Strategic Advances of Hydrogel Dressings for Chronic Wound Management. ACS Omega 2023, 8, 8172–8189. [Google Scholar] [CrossRef]
- Ahmed, E.M. Hydrogel: Preparation, characterization, and applications: A review. J. Adv. Res. 2015, 6, 105–121. [Google Scholar] [CrossRef]
- Louf, J.-F.; Lu, N.B.; O’connell, M.G.; Cho, H.J.; Datta, S.S. Under pressure: Hydrogel swelling in a granular medium. Sci. Adv. 2021, 7, 2711. [Google Scholar] [CrossRef]
- Jia, B.; Li, G.; Cao, E.; Luo, J.; Zhao, X.; Huang, H. Recent progress of antibacterial hydrogels in wound dressings. Mater. Today Bio 2023, 19, 100582. [Google Scholar] [CrossRef]
- Fernandes, A.; Rodrigues, P.M.; Pintado, M.; Tavaria, F.K. A systematic review of natural products for skin applications: Targeting inflammation, wound healing, and photo-aging. Phytomedicine 2023, 115, 154824. [Google Scholar] [CrossRef]
- He, J.J.; McCarthy, C.; Camci-Unal, G. Development of Hydrogel-Based Sprayable Wound Dressings for Second-and Third-Degree Burns. Adv. NanoBiomed Res. 2021, 1, 2100004. [Google Scholar] [CrossRef]
- Li, S.; Dong, S.; Xu, W.; Tu, S.; Yan, L.; Zhao, C.; Ding, J.; Chen, X. Antibacterial Hydrogels. Adv. Sci. 2018, 5, 1700527. [Google Scholar] [CrossRef] [PubMed]
- Pérez-Luna, V.H.; González-Reynoso, O. Encapsulation of Biological Agents in Hydrogels for Therapeutic Applications. Gels 2018, 4, 61. [Google Scholar] [CrossRef] [PubMed]
- Alkekhia, D.; LaRose, C.; Shukla, A. β-Lactamase-Responsive hydrogel drug delivery platform for bacteria-triggered cargo release. ACS Appl. Mater. Interfaces 2022, 14, 27538–27550. [Google Scholar] [CrossRef] [PubMed]
- Baghersad, S.; Hivechi, A.; Bahrami, S.H.; Milan, P.B.; Siegel, R.A.; Amoupour, M. Optimal Aloe vera encapsulated PCL/Gel nanofiber design for skin substitute application and the evaluation of its in vivo implantation. J. Drug Deliv. Sci. Technol. 2022, 74, 103536. [Google Scholar] [CrossRef]
- Balaji, A.; Vellayappan, M.V.; John, A.A.; Subramanian, A.P.; Jaganathan, S.K.; SelvaKumar, M.; Faudzi, A.A.B.M.; Supriyanto, E.; Yusof, M. Biomaterials based nano-applications of Aloe vera and its perspective: A review. RSC Adv. 2015, 5, 86199–86213. [Google Scholar] [CrossRef]
- Yadeta, A.T. Food applications of Aloe species: A review. J. Plant Sci. Phytopathol. 2022, 6, 24–32. [Google Scholar] [CrossRef]
- Rahman, S.; Carter, P.; Bhattarai, N. Aloe vera for Tissue Engineering Applications. J. Funct. Biomater. 2017, 8, 6. [Google Scholar] [CrossRef] [PubMed]
- Minjares-Fuentes, R.; Femenia, A. Chapter 3.4-Aloe vera. In Nonvitamin and Nonmineral Nutritional Supplements; Nabavi, S.M., Silva, A.S., Eds.; Academic Press: Cambridge, MA, USA, 2019; pp. 145–152. [Google Scholar] [CrossRef]
- Enachi, E.; Boev, M.; Bahrim, G. Aloe vera plant-an important source of bioactive compounds with functional value. Innov. Rom. Food Biotechnol. 2020, 19, 1–20. Available online: https://www.gup.ugal.ro/ugaljournals/index.php/IFRB/article/view/4309 (accessed on 22 May 2023).
- Khan, R.U.; Naz, S.; De Marzo, D.; Dimuccio, M.M.; Bozzo, G.; Tufarelli, V.; Losacco, C.; Ragni, M. Aloe vera: A Sustainable Green Alternative to Exclude Antibiotics in Modern Poultry Production. Antibiotics 2023, 12, 44. [Google Scholar] [CrossRef]
- Sánchez, M.; González-Burgos, E.; Iglesias, I.; Gómez-Serranillos, M.P. Pharmacological Update Properties of Aloe vera and its Major Active Constituents. Molecules 2020, 25, 1324. [Google Scholar] [CrossRef]
- Massoud, D.; Alrashdi, B.M.; Fouda, M.M.A.; El-Kott, A.; Soliman, S.A.; Abd-Elhafeez, H.H. Aloe vera and wound healing: A brief review. Braz. J. Pharm. Sci. 2022, 58, e20837. [Google Scholar] [CrossRef]
- Pressman, P.; Clemens, R.; Hayes, A.W. Aloe vera at the frontier of glycobiology and integrative medicine: Health implications of an ancient plant. SAGE Open Med. 2019, 7, 2050312119875921. [Google Scholar] [CrossRef] [PubMed]
- Babu, S.N.; Noor, A. Bioactive constituents of the genus Aloe and their potential therapeutic and pharmacological applications: A review. J. Appl. Pharm. Sci. 2020, 10, 133–145. [Google Scholar]
- Suriati, L. Nano Coating of Aloe-Gel Incorporation Additives to Maintain the Quality of Freshly Cut Fruits. Front. Sustain. Food Syst. 2022, 6, 914254. [Google Scholar] [CrossRef]
- Godoy, D.J.D.; Chokboribal, J.; Pauwels, R.; Banlunara, W.; Sangvanich, P.; Jaroenporn, S.; Thunyakitpisal, P. Acemannan increased bone surface, bone volume, and bone density in a calvarial defect model in skeletally-mature rats. J. Dent. Sci. 2018, 13, 334–341. [Google Scholar] [CrossRef]
- Wang, X.-F.; Chen, X.; Tang, Y.; Wu, J.-M.; Qin, D.-L.; Yu, L.; Yu, C.-L.; Zhou, X.-G.; Wu, A.-G. The Therapeutic Potential of Plant Polysaccharides in Metabolic Diseases. Pharmaceuticals 2022, 15, 1329. [Google Scholar] [CrossRef] [PubMed]
- Sabbaghzadegan, S.; Golsorkhi, H.; Soltani, M.H.; Kamalinejad, M.; Bahrami, M.; Kabir, A.; Dadmehr, M. Potential protective effects of Aloe vera gel on cardiovascular diseases: A mini-review. Phytother. Res. 2021, 35, 6101–6113. [Google Scholar] [CrossRef]
- Lissoni, P.; Rovelli, F.; Brivio, F.; Zago, R.; Colciago, M.; Messina, G.; Mora, A.; Porro, G. A randomized study of chemotherapy versus biochemotherapy with chemotherapy plus Aloe arborescens in patients with metastatic cancer. Vivo 2009, 23, 171–175. [Google Scholar]
- Thant, A.A.; Ruangpornvisuti, V.; Sangvanich, P.; Banlunara, W.; Limcharoen, B.; Thunyakitpisal, P. Characterization of a bioscaffold containing polysaccharide acemannan and native collagen for pulp tissue regeneration. Int. J. Biol. Macromol. 2023, 225, 286–297. [Google Scholar] [CrossRef]
- Madrid, R.R.M.; Mathews, P.D.; Pimenta, B.V.; Mertins, O. Biopolymer–Lipid Hybrid Cubosome for Delivery of Acemannan. Mater. Proc. 2023, 14, 56. [Google Scholar] [CrossRef]
- Suciati, T.; Rachmawati, P.; Soraya, E.; Mahardhika, A.B.; Hartarti, R.; Anggadiredja, K. A novel acemannan-chitosan modified lipid nanoparticles as intracellular delivery vehicles of antibiotic. J. Appl. Pharm. Sci. 2018, 8, 1–11. [Google Scholar]
- Cataldi, V.; Di Bartolomeo, S.; Di Campli, E.; Nostro, A.; Cellini, L.; Di Giulio, M. In vitro activity of Aloe vera inner gel against microorganisms grown in planktonic and sessile phases. Int. J. Immunopathol. Pharmacol. 2015, 28, 595–602. [Google Scholar] [CrossRef]
- Leitgeb, M.; Kupnik, K.; Knez, Ž.; Primožič, M. Enzymatic and Antimicrobial Activity of Biologically Active Samples from Aloe arborescens and Aloe barbadensis. Biology 2021, 10, 765. [Google Scholar] [CrossRef]
- Yahya, R.; Al-Rajhi, A.M.H.; Alzaid, S.Z.; Al Abboud, M.A.; Almuhayawi, M.S.; Al Jaouni, S.K.; Selim, S.; Ismail, K.S.; Abdelghany, T.M. Molecular Docking and Efficacy of Aloe vera Gel Based on Chitosan Nanoparticles against Helicobacter pylori and Its Antioxidant and Anti-Inflammatory Activities. Polymers 2022, 14, 2994. [Google Scholar] [CrossRef] [PubMed]
- Yazdani, N.; Hossini, S.E.; Edalatmanesh, M.A. Anti-inflammatory Effect of Aloe vera Extract on Inflammatory Cytokines of Rats Fed with a High-Fat Diet (HFD). Jundishapur J. Nat. Pharm. Prod. 2022, 17, e114323. [Google Scholar] [CrossRef]
- Fani, M.; Kohanteb, J. Inhibitory activity of Aloe vera gel on some clinically isolated cariogenic and periodontopathic bacteria. J. Oral Sci. 2012, 54, 15–21. [Google Scholar] [CrossRef] [PubMed]
- Haghani, F.; Arabnezhad, M.-R.; Mohammadi, S.; Ghaffarian-Bahraman, A. Aloe vera and Streptozotocin-Induced Diabetes Mellitus. Rev. Bras. Farm. 2022, 32, 174–187. [Google Scholar] [CrossRef] [PubMed]
- Chimisso, V.; Aleman Garcia, M.A.; Yorulmaz Avsar, S.; Dinu, I.A.; Palivan, C.G. Design of Bio-Conjugated Hydrogels for Regenerative Medicine Applications: From Polymer Scaffold to Biomolecule Choice. Molecules 2020, 25, 4090. [Google Scholar] [CrossRef]
- Pereira, R.; Mendes, A.; Bártolo, P. Alginate/Aloe vera Hydrogel Films for Biomedical Applications. Procedia CIRP 2013, 5, 210–215. [Google Scholar] [CrossRef]
- Liu, Y.; Fan, J.; Lv, M.; She, K.; Sun, J.; Lu, Q.; Han, C.; Ding, S.; Zhao, S.; Wang, G.; et al. Photocrosslinking silver nanoparticles–Aloe vera–silk fibroin composite hydrogel for treatment of full-thickness cutaneous wounds. Regen. Biomater. 2021, 8, rbab048. [Google Scholar] [CrossRef]
- Yang, K.; Han, Q.; Chen, B.; Zheng, Y.; Zhang, K.; Li, Q.; Wang, J. Antimicrobial hydrogels: Promising materials for medical application. Int. J. Nanomed. 2018, 13, 2217–2263. [Google Scholar] [CrossRef]
- Azahra, S.; Parisa, N.; Fatmawati, F.; Amalia, E.; Larasati, V. Antibacterial Efficacy of Aloe vera Sap Against Staphylococcus aureus and Escherichia coli. Biosci. Med. J. Biomed. Transl. Res. 2019, 3, 29–37. [Google Scholar] [CrossRef]
- Huang, C.; Dong, L.; Zhao, B.; Lu, Y.; Huang, S.; Yuan, Z.; Luo, G.; Xu, Y.; Qian, W. Anti-inflammatory hydrogel dressings and skin wound healing. Clin. Transl. Med. 2022, 12, e1094. [Google Scholar] [CrossRef] [PubMed]
- Kim, M.W.; Kang, J.-H.; Shin, E.; Shim, K.-S.; Kim, M.J.; Lee, C.-K.; Yoon, Y.S.; Oh, S.H. Processed Aloe vera gel attenuates non-steroidal anti-inflammatory drug (NSAID)-induced small intestinal injury by enhancing mucin expression. Food Funct. 2019, 10, 6088–6097. [Google Scholar] [CrossRef] [PubMed]
- Bialik-Wąs, K.; Raftopoulos, K.N.; Pielichowski, K. Alginate Hydrogels with Aloe vera: The Effects of Reaction Temperature on Morphology and Thermal Properties. Materials 2022, 15, 748. [Google Scholar] [CrossRef] [PubMed]
- Chelu, M.; Popa, M.; Ozon, E.A.; Cusu, J.P.; Anastasescu, M.; Surdu, V.A.; Moreno, J.C.; Musuc, A.M. High-Content Aloe vera Based Hydrogels: Physicochemical and Pharmaceutical Properties. Polymers 2023, 15, 1312. [Google Scholar] [CrossRef]
- Kahramanoğlu, I.; Chen, C.; Chen, J.; Wan, C. Chemical Constituents, Antimicrobial Activity, and Food Preservative Characteristics of Aloe vera Gel. Agronomy 2019, 9, 831. [Google Scholar] [CrossRef]
- Radha, M.H.; Laxmipriya, N.P. Evaluation of biological properties and clinical effectiveness of Aloe vera: A systematic review. J. Tradit. Complement. Med. 2014, 5, 21–26. [Google Scholar] [CrossRef]
- Pop, R.M.; Puia, I.C.; Puia, A.; Chedea, V.S.; Levai, A.M.; Bocsan, I.C.; Buzoianu, A.D. Pot Aloe vera gel–a natural source of antioxidants. Not. Bot. Horti Agrobot. Cluj Napoca 2022, 50, 12732. [Google Scholar] [CrossRef]
- Flores-López, M.L.; Romaní, A.; Cerqueira, M.A.; Rodríguez-García, R.; Jasso de Rodríguez, D.; Vicente, A.A. Compositional features and bioactive properties of whole fraction from Aloe vera processing. Ind. Crops Prod. 2016, 91, 179–185. [Google Scholar] [CrossRef]
- Ahlawat, K.S.; Khatkar, B.S. Processing, food applications and safety of Aloe vera products: A review. J. Food Sci. Technol. 2011, 48, 525–533. [Google Scholar] [CrossRef] [PubMed]
- Rahoui, W.; Merzouk, H.; El Haci, I.A.; Bettioui, R.; Azzi, R.; Benali, M. Beneficial effects of Aloe vera gel on lipid profile, lipase activities and oxidant/antioxidant status in obese rats. J. Funct. Foods 2018, 48, 525–532. [Google Scholar] [CrossRef]
- Cavasana, A.L.; dos Santos, C.H.M.; Dourado, D.M.; Guimarães, F.D.S.; Barros, F.H.R.; de Campos, G.C.O.; Leme, G.A.L.; da Silva, L.D.M.; Wahl, L.M.; Gutterres, N.B.D.A.; et al. Effectiveness of the Aloe vera extract in the treatment of fistula-in-ano. J. Coloproctology 2020, 40, 67–72. [Google Scholar] [CrossRef]
- Khedmat, H.; Karbasi, A.; Amini, M.; Aghaei, A.; Taheri, S. Aloe vera in treatment of refractory irritable bowel syndrome: Trial on Iranian patients. J. Res. Med. Sci. 2013, 18, 732. [Google Scholar]
- Le Phan, T.H.; Park, S.Y.; Jung, H.J.; Kim, M.W.; Cho, E.; Shim, K.-S.; Shin, E.; Yoon, J.-H.; Maeng, H.-J.; Kang, J.-H.; et al. The Role of Processed Aloe vera Gel in Intestinal Tight Junction: An In Vivo and In Vitro Study. Int. J. Mol. Sci. 2021, 22, 6515. [Google Scholar] [CrossRef]
- López-Cervantes, J.; Sánchez-Machado, D.I.; Cruz-Flores, P.; Mariscal-Domínguez, M.F.; de la Mora-López, G.S.; Campas-Baypoli, O.N. Antioxidant capacity, proximate composition, and lipid constituents of Aloe vera flowers. J. Appl. Res. Med. Aromat. Plants 2018, 10, 93–98. [Google Scholar] [CrossRef]
- Shakib, Z.; Shahraki, N.; Razavi, B.M.; Hosseinzadeh, H. Aloe vera as an herbal medicine in the treatment of metabolic syndrome: A review. Phytother. Res. 2019, 33, 2649–2660. [Google Scholar] [CrossRef]
- Parlati, L.; Voican, C.S.; Perlemuter, K.; Perlemuter, G. Aloe vera -induced acute liver injury: A case report and literature review. Clin. Res. Hepatol. Gastroenterol. 2017, 41, e39–e42. [Google Scholar] [CrossRef]
- Guha, P.; Subhashis, P.; Das, A.; Halder, B.; Bhattacharjee, S.; Chaudhuri, T.K. Analyses of Human and Rat Clinical Parameters in Rheumatoid Arthritis Raise the Possibility of Use of Crude Aloe vera Gel in Disease Amelioration. Immunome Res. 2014, 10, 81. [Google Scholar] [CrossRef]
- Majumder, R.; Das, C.K.; Mandal, M. Lead bioactive compounds of Aloe vera as potential anticancer agent. Pharmacol. Res. 2019, 148, 104416. [Google Scholar] [CrossRef]
- El Salam, H.A.; Megahed, H.; El Aziz, S.A.; Sobhy, M.; El-Mouaty, H.A. Comparative Study of the Possible Hepatoprotective Effect of Each of N-acetylcysteine, Coenzyme Q10 and Aloe vera Gel in Acute Acetaminophen Induced Hepatotoxicity in Albino Rats. (Histological and Biochemical Study). Ain Shams J. Forensic Med. Clin. Toxicol. 2014, 23, 115–138. [Google Scholar] [CrossRef]
- Şehitoğlu, M.H.; Karaboga, I.; Kiraz, A.; Kiraz, H.A. The hepatoprotective effect of Aloe vera on ischemia-reperfusion injury in rats. North. Clin. Istanb. 2018, 6, 203–209. [Google Scholar] [CrossRef] [PubMed]
- Salehi, B.; Albayrak, S.; Antolak, H.; Kręgiel, D.; Pawlikowska, E.; Sharifi-Rad, M.; Uprety, Y.; Fokou, P.V.T.; Yousef, Z.; Zakaria, Z.A.; et al. Aloe Genus Plants: From Farm to Food Applications and Phytopharmacotherapy. Int. J. Mol. Sci. 2018, 19, 2843. [Google Scholar] [CrossRef] [PubMed]
- Sujatha, G.; Kumar, G.S.; Muruganandan, J.; Prasad, T.S. Aloe vera in Dentistry. J. Clin. Diagn. Res. 2014, 8, ZI01–ZI02. [Google Scholar] [CrossRef]
- Mangaiyarkarasi, S.P.; Manigandan, T.; Elumalai, M.; Cholan, P.K.; Kaur, R.P. Benefits of Aloe vera in dentistry. J Pharm Bioallied Sci. 2015, 7 (Suppl. S1), S255–S259. [Google Scholar] [CrossRef]
- Nair, G.R.; Naidu, G.S.; Jain, S.; Nagi, R.; Makkad, R.S.; Jha, A. Clinical Effectiveness of Aloe vera in the Management of Oral Mucosal Diseases- A Systematic Review. J. Clin. Diagn. Res. 2016, 10, ZE01–ZE07. [Google Scholar] [CrossRef]
- Sholehvar, F.; Mehrabani, D.; Yaghmaei, P.; Vahdati, A. The effect of Aloe veragel on viability of dental pulp stem cells. Dent. Traumatol. 2016, 32, 390–396. [Google Scholar] [CrossRef]
- Songsiripradubboon, S.; Kladkaew, S.; Trairatvorakul, C.; Sangvanich, P.; Soontornvipart, K.; Banlunara, W.; Thunyakitpisal, P. Stimulation of Dentin Regeneration by Using Acemannan in Teeth with Lipopolysaccharide-induced Pulp Inflammation. J. Endod. 2017, 43, 1097–1103. [Google Scholar] [CrossRef]
- Aparicio Salcedo, S.V.; Carranza Aldana, B.S.; Chávez Salas, S.A.; Quispe Tinco, L.S.; Palomino Zevallos, C.A.; Peralta Medina, A.N.; Robles Esquerre, J.M. Pharmacological efficacy of Aloe vera in wound healing: A narrative review: Eficacia farmacológica del Aloe vera en la cicatrización de heridas: Una revisión narrativa. Rev. Fac. Med. Hum. 2023, 23, 110–120. [Google Scholar] [CrossRef]
- Vinson, J.; Al Kharrat, H.; Andreoli, L. Effect of Aloe vera preparations on the human bioavailability of vitamins C and E. Phytomedicine 2005, 12, 760–765. [Google Scholar] [CrossRef]
- Rompicherla, N.C.; Joshi, P.; Shetty, A.; Sudhakar, K.; Amin, H.I.M.; Mishra, Y.; Mishra, V.; Albutti, A.; Alhumeed, N. Design, Formulation, and Evaluation of Aloe vera Gel-Based Capsaicin Transemulgel for Osteoarthritis. Pharmaceutics 2022, 14, 1812. [Google Scholar] [CrossRef] [PubMed]
- Valizadeh, A.; Darvishi, M.H.; Amani, A.; Zarchi, A.A.K. Design and development of novel formulation of Aloe vera nanoemulsion gel contained erythromycin for topical antibacterial therapy: In vitro and in vivo assessment. J. Drug Deliv. Sci. Technol. 2022, 74, 103519. [Google Scholar] [CrossRef]
- Nabipour, H.; Rohani, S. Zirconium metal organic framework/Aloe vera carrier loaded with naproxen as a versatile platform for drug delivery. Chem. Pap. 2023, 77, 3461–3470. [Google Scholar] [CrossRef]
- Lin, C.-C.; Metters, A.T. Hydrogels in controlled release formulations: Network design and mathematical modeling. Adv. Drug Deliv. Rev. 2006, 58, 1379–1408. [Google Scholar] [CrossRef]
- Bettini, R.; Colombo, P.; Massimo, G.; Catellani, P.L.; Vitali, T. Swelling and drug release in hydrogel matrices: Polymer viscosity and matrix porosity effects. Eur. J. Pharm. Sci. 1994, 2, 213–219. [Google Scholar] [CrossRef]
- Dadashzadeh, A.; Imani, R.; Moghassemi, S.; Omidfar, K.; Abolfathi, N. Study of hybrid alginate/gelatin hydrogel-incorporated niosomal Aloe vera capable of sustained release of Aloe vera as potential skin wound dressing. Polym. Bull. 2020, 77, 387–403. [Google Scholar] [CrossRef]
- Meng, R.; Zhu, H.; Deng, P.; Li, M.; Ji, Q.; He, H.; Jin, L.; Wang, B. Research progress on albumin-based hydrogels: Properties, preparation methods, types and its application for antitumor-drug delivery and tissue engineering. Front. Bioeng. Biotechnol. 2023, 11, 1137145. [Google Scholar] [CrossRef]
- Armstrong, A.W.; Read, C. Pathophysiology, clinical presentation, and treatment of psoriasis: A review. JAMA 2020, 323, 1945–1960. [Google Scholar] [CrossRef]
- Jales, S.T.L.; Barbosa, R.D.M.; de Albuquerque, A.C.; Duarte, L.H.V.; da Silva, G.R.; Meirelles, L.M.A.; da Silva, T.M.S.; Alves, A.F.; Viseras, C.; Raffin, F.N.; et al. Development and Characterization of Aloe vera Mucilaginous-Based Hydrogels for Psoriasis Treatment. J. Compos. Sci. 2022, 6, 231. [Google Scholar] [CrossRef]
- Herculano, R.D.; dos Santos, T.O.; de Barros, N.R.; Brasil, G.S.P.; Scontri, M.; Carvalho, B.G.; Mecwan, M.; Farhadi, N.; Kawakita, S.; Perego, C.H.; et al. Aloe vera-loaded natural rubber latex dressing as a potential complementary treatment for psoriasis. Int. J. Biol. Macromol. 2023, 242, 124779. [Google Scholar] [CrossRef]
- Sharma, K.; Munjal, M.; Sharma, R.K.; Sharma, M. Thymol encapsulated chitosan-Aloe vera films for antimicrobial infection. Int. J. Biol. Macromol. 2023, 30, 123897. [Google Scholar] [CrossRef]
- Ghafoor, B.; Ali, M.N.; Ansari, U.; Bhatti, M.F.; Mir, M.; Akhtar, H.; Darakhshan, F. New Biofunctional Loading of Natural Antimicrobial Agent in Biodegradable Polymeric Films for Biomedical Applications. Int. J. Biomater. 2016, 2016, 6964938. [Google Scholar] [CrossRef] [PubMed]
- Thomas, T.; Nath, M.S.; Mathew, N.; Reshmy, R.; Philip, E.; Latha, M.S. Alginate film modified with aloevera gel and cellulose nanocrystals for wound dressing application: Preparation, characterization and in vitro evaluation. J. Drug Deliv. Sci. Technol. 2020, 59, 101894. [Google Scholar] [CrossRef]
- Yin, J.; Xu, L. Batch preparation of electrospun polycaprolactone/chitosan/Aloe vera blended nanofiber membranes for novel wound dressing. Int. J. Biol. Macromol. 2020, 160, 352–363. [Google Scholar] [CrossRef]
- Barbosa, R.; Villarreal, A.; Rodriguez, C.; De Leon, H.; Gilkerson, R.; Lozano, K. Aloe vera extract-based composite nanofibers for wound dressing applications. Mater. Sci. Eng. C 2021, 124, 112061. [Google Scholar] [CrossRef]
- Bialik-Wąs, K.; Pluta, K.; Malina, D.; Barczewski, M.; Malarz, K.; Mrozek-Wilczkiewicz, A. Advanced SA/PVA-based hydrogel matrices with prolonged release of Aloe vera as promising wound dressings. Mater. Sci. Eng. C 2021, 120, 111667. [Google Scholar] [CrossRef]
- Goudarzi, M.; Fazeli, M.; Azad, M.; Seyedjavadi, S.S.; Mousavi, R. Aloe vera Gel: Effective Therapeutic Agent against Multidrug-Resistant Pseudomonas aeruginosa Isolates Recovered from Burn Wound Infections. Chemother. Res. Pract. 2015, 2015, 639806. [Google Scholar] [CrossRef]
- Susanto, C.; Purba, M.R.; Mahrani, R.; Efendi, R. Efficacy of Aloe vera Hydrogel in Inhibition The Growth of Campylobacter rectus and Provetella intermedia Bacteria. Biosci. Med. J. Biomed. Transl. Res. 2021, 5, 784–790. [Google Scholar] [CrossRef]
- Singh, S.; Anjum, S.; Joy, J.; Gupta, B. Polysaccharide–Aloe vera Bioactive Hydrogels as Wound Care System. In Cellulose-Based Superabsorbent Hydrogels. Polymers and Polymeric Composites: A Reference Series; Mondal, M., Ed.; Springer: Cham, Switzerland, 2018. [Google Scholar] [CrossRef]
- Abdo, J.M.; Sopko, N.A.; Milner, S.M. The applied anatomy of human skin: A model for regeneration. Wound Med. 2020, 28, 100179. [Google Scholar] [CrossRef]
- Hofmann, E.; Schwarz, A.; Fink, J.; Kamolz, L.-P.; Kotzbeck, P. Modelling the Complexity of Human Skin In Vitro. Biomedicines 2023, 11, 794. [Google Scholar] [CrossRef]
- Swaney, M.H.; Kalan, L.R. Living in Your Skin: Microbes, Molecules, and Mechanisms. Infect. Immun. 2021, 89, e00695-20. [Google Scholar] [CrossRef] [PubMed]
- Byrd, A.L.; Belkaid, Y.; Segre, J.A. The human skin microbiome. Nat. Rev. Microbiol. 2018, 16, 143–155. [Google Scholar] [CrossRef]
- Sen, C.K. Human Wound and its Burden: Updated 2020 Compendium of Estimates. Adv. Wound Care 2021, 10, 281–292. [Google Scholar] [CrossRef] [PubMed]
- Grubbs, H.; Manna, B. Wound Physiology. In StatPearls; StatPearls Publishing: Treasure Island, FL, USA, 2023. Available online: https://www.ncbi.nlm.nih.gov/books/NBK518964/ (accessed on 22 May 2023).
- Harper, D.; Young, A.; McNaught, C.-E. The physiology of wound healing. Surgery 2014, 32, 445–450. [Google Scholar] [CrossRef]
- Tavakoli, S.; Klar, A.S. Advanced Hydrogels as Wound Dressings. Biomolecules 2020, 10, 1169. [Google Scholar] [CrossRef]
- Gosain, A.; DiPietro, L.A. Aging and wound healing. World J. Surg. 2004, 28, 321–326. [Google Scholar] [CrossRef] [PubMed]
- Merabet, N.; Lucassen, P.J.; Crielaard, L.; Stronks, K.; Quax, R.; Sloot, P.M.; la Fleur, S.E.; Nicolaou, M. How exposure to chronic stress contributes to the development of type 2 diabetes: A complexity science approach. Front. Neuroendocr. 2022, 65, 100972. [Google Scholar] [CrossRef]
- Eming, S.A.; Murray, P.J.; Pearce, E.J. Metabolic orchestration of the wound healing response. Cell Metab. 2021, 33, 1726–1743. [Google Scholar] [CrossRef]
- El-Ashram, S.; El-Samad, L.M.; Basha, A.A.; El Wakil, A. Naturally-derived targeted therapy for wound healing: Beyond classical strategies. Pharmacol. Res. 2021, 170, 105749. [Google Scholar] [CrossRef]
- Wang, Y.; Zhang, Y.; Lin, Z.; Huang, T.; Li, W.; Gong, W.; Guo, Y.; Su, J.; Wang, J.; Tu, Q. A green method of preparing a natural and degradable wound dressing containing Aloe vera as an active ingredient. Compos. Part B Eng. 2021, 222, 109047. [Google Scholar] [CrossRef]
- Paul, K.; Darzi, S.; Del Borgo, M.P.; Cousins, F.L.; Werkmeister, J.A.; Gargett, C.E.; Mukherjee, S. Vaginal delivery of tissue engineered endometrial mesenchymal stem/stromal cells in an Aloe vera-alginate hydrogel alleviates maternal simulated birth injury. Appl. Mater. Today 2021, 22, 100890. [Google Scholar] [CrossRef]
- Alsareii, S.A.; Ahmad, J.; Umar, A.; Ahmad, M.Z.; Shaikh, I.A. Enhanced In Vivo Wound Healing Efficacy of a Novel Piperine-Containing Bioactive Hydrogel in Excision Wound Rat Model. Molecules 2023, 28, 545. [Google Scholar] [CrossRef] [PubMed]
- Meza-Valle, K.Z.; Saucedo-Acuña, R.A.; Tovar-Carrillo, K.L.; Cuevas-González, J.C.; Zaragoza-Contreras, E.A.; Melgoza-Lozano, J. Characterization and Topical Study of Aloe vera Hydrogel on Wound-Healing Process. Polymers 2021, 13, 3958. [Google Scholar] [CrossRef]
- Chelu, M.; Musuc, A.M.; Aricov, L.; Ozon, E.A.; Iosageanu, A.; Stefan, L.M.; Prelipcean, A.-M.; Popa, M.; Moreno, J.C. Antibacterial Aloe vera Based Biocompatible Hydrogel for Use in Dermatological Applications. Int. J. Mol. Sci. 2023, 24, 3893. [Google Scholar] [CrossRef]
- Khorasani, G.; Hosseinimehr, S.J.; Azadbakht, M.; Zamani, A.; Mahdavi, M.R. Aloe versus silver sulfadiazine creams for second-degree burns: A randomized controlled study. Surg. Today 2009, 39, 587–591. [Google Scholar] [CrossRef] [PubMed]
- Shahzad, M.N.; Ahmed, N. Effectiveness of Aloe vera gel compared with 1% silver sulphadiazine cream as burn wound dressing in second degree burns. J. Pak. Med. Assoc. 2013, 63, 225–230. [Google Scholar]
- Panahi, Y.; Beiraghdar, F.; Akbari, H.; Bekhradi, H.; Taghizadeh, M.; Sahebkar, A. A herbal cream consisting of Aloe vera, Lavandula stoechas, and Pelargonium roseum as an alternative for silver sulfadiazine in burn management. Asian Biomed. 2012, 6, 273–278. [Google Scholar] [CrossRef]
- Avijgan, M.; Alinaghian, M.; Esfahani, M.H. Aloe vera Gel as a Traditional and Complementary Method for Chronic Skin Burn: A Case Report. Adv. Infect. Dis. 2017, 7, 19–25. [Google Scholar] [CrossRef]
- Tungkasamit, T.; Chakrabandhu, S.; Samakgarn, V.; Kunawongkrit, N.; Jirawatwarakul, N.; Chumachote, A.; Chitapanarux, I. Reduction in severity of radiation-induced dermatitis in head and neck cancer patients treated with topical Aloe vera gel: A randomized multicenter double-blind placebo-controlled trial. Eur. J. Oncol. Nurs. 2022, 59, 102164. [Google Scholar] [CrossRef]
- Dal’Belo, S.E.; Gaspar, L.R.; Maia Campos, P.M. Moisturizing effect of cosmetic formulations containing Aloe vera extract in different concentrations assessed by skin bioengineering techniques. Ski. Res. Technol. 2006, 12, 241–246. [Google Scholar] [CrossRef]
- Zhang, L.; Tizard, I.R. Activation of a mouse macrophage cell line by acemannan: The major carbohydrate fraction from Aloe vera gel. Immunopharmacology 1996, 35, 119–128. [Google Scholar] [CrossRef] [PubMed]
- Ma, Y.; Tang, T.; Sheng, L.; Wang, Z.; Tao, H.; Zhang, Q.; Qi, Z. Aloin suppresses lipopolysaccharide-induced inflammation by inhibiting JAK1-STAT1/3 activation and ROS production in RAW264. 7 cells. Int. J. Mol. Med. 2018, 42, 1925–1934. [Google Scholar]
- Leng, H.; Pu, L.; Xu, L.; Shi, X.; Ji, J.; Chen, K. Effects of Aloe polysaccharide, a polysaccharide extracted from Aloe vera, on TNF-α-induced HaCaT cell proliferation and the underlying mechanism in psoriasis. Mol. Med. Rep. 2018, 18, 3537–3543. [Google Scholar] [CrossRef]
- Jiang, K.; Guo, S.; Yang, C.; Yang, J.; Chen, Y.; Shaukat, A.; Deng, G. Barbaloin protects against lipopolysaccharide (LPS)-induced acute lung injury by inhibiting the ROS-mediated PI3K/AKT/NF-κB pathway. Int. Immunopharm. 2018, 64, 140–150. [Google Scholar] [CrossRef] [PubMed]
- Paul, S.; Modak, D.; Chattaraj, S.; Nandi, D.; Sarkar, A.; Roy, J.; Chaudhuri, T.K.; Bhattacharjee, S. Aloe vera gel homogenate shows anti-inflammatory activity through lysosomal membrane stabilization and downregulation of TNF-α and Cox-2 gene expressions in inflammatory arthritic animals. Futur. J. Pharm. Sci. 2021, 7, 12. [Google Scholar] [CrossRef]
- Ahluwalia, B.; Magnusson, M.K.; Isaksson, S.; Larsson, F.; Öhman, L. Effects of Aloe barbadensis Mill. extract (AVH200®) on human blood T cell activity in vitro. J. Ethnopharm. 2016, 179, 301–309. [Google Scholar] [CrossRef]
- Moriyama, M.; Moriyama, H.; Uda, J.; Kubo, H.; Nakajima, Y.; Goto, A.; Akaki, J.; Yoshida, I.; Matsuoka, N.; Hayakawa, T. Beneficial effects of the genus aloe on wound healing, cell proliferation, and differentiation of epidermal keratinocytes. PLoS ONE 2016, 11, e0164799. [Google Scholar] [CrossRef]
- Liu, L.Y.; Chen, X.D.; Wu, B.; Jiang, Q. Influence of Aloe polysaccharide on proliferation and hyaluronic acid and hydroxyproline secretion of human fibroblasts in vitro. J. Chin. Integr. Med. 2010, 8, 256–262. [Google Scholar] [CrossRef]
- Hamid, A.A.A.; Soliman, M.F. Effect of topical Aloe vera on the process of healing of full-thickness skin burn: A histological and immunohistochemical study. J. Histol. Histopathol. 2015, 2, 3. [Google Scholar] [CrossRef]
- Hashemi, S.A.; Madani, S.A.; Abediankenari, S. The Review on properties of Aloe vera in healing of cutaneous wounds. BioMed Res. Int. 2015, 2015, 714216. [Google Scholar] [CrossRef]
- Maenthaisong, R.; Chaiyakunapruk, N.; Niruntraporn, S.; Kongkaew, C. The efficacy of Aloe vera used for burn wound healing: A systematic review. Burns 2007, 33, 713–718. [Google Scholar] [CrossRef]
- Moghbel, A.; Ghalambor, A.; Allipanah, S. Wound healing and toxicity evaluation of Aloe vera cream on outpatients with second degree burns. Iran. J. Pharm. Sci. Summer 2007, 3, 157–160. [Google Scholar]
- Somboonwong, J.; Thanamittramanee, S.; Jariyapongskul, A.; Patumraj, S. Therapeutic effects of Aloe vera on cutaneous microcirculation and wound healing in second degree burn model in rats. J. Med. Assoc. Thail. 2000, 83, 417–425. [Google Scholar]
- Fox, L.T.; du Plessis, J.; Gerber, M.; van Zyl, S.; Boneschans, B.; Hamman, J.H. In Vivo skin hydration and anti-erythema effects of Aloe vera, Aloe ferox and Aloe marlothii gel materials after single and multiple applications. Pharmacogn. Mag. 2014, 10 (Suppl. S2), S392–S403. [Google Scholar] [CrossRef]
- Moon, E.-J.; Lee, Y.M.; Lee, O.-H.; Lee, M.-J.; Lee, S.-K.; Chung, M.-H.; Park, Y.-I.; Sung, C.-K.; Choi, J.-S.; Kim, K.-W. A ncovel angiogenic factor derived from Aloe vera gel: β-sitosterol, a plant sterol. Angiogenesis 1999, 3, 117–123. [Google Scholar] [CrossRef]
- Choi, S.; Kim, K.-W.; Choi, J.-S.; Han, S.-T.; Park, Y.-I.; Lee, S.-K.; Kim, J.-S.; Chung, M.-H. Angiogenic activity of β-sitosterol in the ischaemia/reperfusion-damaged brain of mongolian gerbil. Planta Med. 2002, 68, 330–335. [Google Scholar] [CrossRef]
- Liu, F.-W.; Liu, F.C.; Wang, Y.-R.; Tsai, H.-I.; Yu, H.-P. Aloin protects skin fibroblasts from heat stress-induced oxidative stress damage by regulating the oxidative defense system. PLoS ONE 2015, 10, e0143528. [Google Scholar] [CrossRef] [PubMed]
- Shanmugam, D.K.; Madhavan, Y.; Manimaran, A.; Kaliaraj, G.S.; Mohanraj, K.G.; Kandhasamy, N.; Mosas, K.K.A. Efficacy of Graphene-Based Nanocomposite Gels as a Promising Wound Healing Biomaterial. Gels 2023, 9, 22. [Google Scholar] [CrossRef] [PubMed]
- Teplicki, E.; Ma, Q.; Castillo, D.E.; Zarei, M.; Hustad, A.P.; Chen, J.; Li, J. The Effects of Aloe vera on Wound Healing in Cell Proliferation, Migration, and Viability. Wounds 2018, 30, 263–268. [Google Scholar] [PubMed]
- Negahdari, S.; Galehdari, H.; Kesmati, M.; Rezaie, A.; Shariati, G. Wound healing activity of extracts and formulations of Aloe vera, henna, adiantum capillus-veneris, and myrrh on mouse dermal fibroblast cells. Int. J. Prev. Med. 2017, 8, 18. [Google Scholar] [CrossRef]
- Wahedi, H.M.; Jeong, M.; Chae, J.K.; Gil Do, S.; Yoon, H.; Kim, S.Y. Aloesin from Aloe vera accelerates skin wound healing by modulating MAPK/Rho and Smad signaling pathways in vitro and in vivo. Phytomedicine 2017, 28, 19–26. [Google Scholar] [CrossRef]
- Müller-Heupt, L.K.; Wiesmann, N.; Schröder, S.; Korkmaz, Y.; Vierengel, N.; Groß, J.; Dahm, R.; Deschner, J.; Opatz, T.; Brieger, J.; et al. Extracts of Rheum palmatum and Aloe vera Show Beneficial Properties for the Synergistic Improvement of Oral Wound Healing. Pharmaceutics 2022, 14, 2060. [Google Scholar] [CrossRef]
- Hamman, J.H. Composition and Applications of Aloe vera leaf gel. Molecules 2008, 13, 1599–1616. [Google Scholar] [CrossRef] [PubMed]
- Anilakumar, K.R.; Sudarshanakrishnam, K.R.; Chandramohan, G.; Ilaiyaraja, N.; Khanum, F.; Bawa, A.S. Effect of Aloe vera gel extract on antioxidant enzymes and azoxymethane-induced oxidative stress in rats. Indian J. Exp. Biol. 2010, 48, 837–842. [Google Scholar]
- Hassanpour, H. Effect of Aloe vera gel coating on antioxidant capacity, antioxidant enzyme activities and decay in raspberry fruit. LWT Food Sci. Technol. 2015, 60, 495–501. [Google Scholar] [CrossRef]
- Hormozi, M.; Assaei, R.; Boroujeni, M.B. The effect of Aloe vera on the expression of wound healing factors (TGFβ1 and bFGF) in mouse embryonic fibroblast cell: In vitro study. Biomed. Pharmacother. 2017, 88, 610–616. [Google Scholar] [CrossRef]
- Ali, J.; Khan, A.W.; Kotta, S.; Ansari, S.H.; Sharma, R.K.; Kumar, A. Formulation development, optimization and evaluation of Aloe vera gel for wound healing. Pharmacogn. Mag. 2013, 9, 6–10. [Google Scholar] [CrossRef]
- Curto, E.M.; Labelle, A.; Chandler, H.L. Aloe vera: An in vitro study of effects on corneal wound closure and collagenase activity. Vet. Ophthamol. 2014, 17, 403–410. [Google Scholar] [CrossRef]
- De Oliveira, A.C.L.; Tabrez, S.; Shakil, S.; Khan, M.I.; Asghar, M.N.; Matias, B.D.; de Carvalho, R.M. Mutagenic, antioxidant and wound healing properties of Aloe vera. J. Ethnopharmacol. 2018, 227, 191–197. [Google Scholar] [CrossRef]
- Zeng, W.M.; Barnes, C.W.; Hiro, M.E.; Parus, A.; Robson, M.C.; Payne, W.G. Aloe vera—Mechanisms of Action, Uses, and Potential Uses in Plastic Surgery and Wound Healing. Surg. Sci. 2020, 11, 312–328. [Google Scholar] [CrossRef]
- Na, H.S.; Song, Y.R.; Kim, S.; Heo, J.Y.; Chung, H.Y.; Chung, J. Aloin Inhibits Interleukin (IL)-1β− Stimulated IL-8 Production in KB Cells. J. Periodontol. 2016, 87, 108–115. [Google Scholar] [CrossRef] [PubMed]
- Reuter, J.; Jocher, A.; Stump, J.; Grossjohann, B.; Franke, G.; Schempp, C. Investigation of the anti-inflammatory potential of Aloe vera gel (97.5%) in the ultraviolet erythema test. Ski. Pharmacol. Physiol. 2008, 21, 106–110. [Google Scholar] [CrossRef] [PubMed]
- Li, C.-Y.; Suzuki, K.; Hung, Y.-L.; Yang, M.-S.; Yu, C.-P.; Lin, S.-P.; Hou, Y.-C.; Fang, S.-H. Aloe metabolites prevent lps-induced sepsis and inflammatory response by inhibiting mitogen-activated protein kinase activation. Am. J. Chin. Med. 2017, 45, 847–861. [Google Scholar] [CrossRef] [PubMed]
- Pulliero, A.; Profumo, A.; Izzotti, A.; Saccà, S.C. Release of Aloe vera Extracts from Therapeutic Lenses. Appl. Sci. 2020, 10, 9055. [Google Scholar] [CrossRef]
- Chelu, M.; Moreno, J.C.; Atkinson, I.; Cusu, J.P.; Rusu, A.; Bratan, V.; Aricov, L.; Anastasescu, M.; Seciu-Grama, A.-M.; Musuc, A.M. Green synthesis of bioinspired chitosan-ZnO-based polysaccharide gums hydrogels with propolis extract as novel functional natural biomaterials. Int. J. Biol. Macromol. 2022, 211, 410–424. [Google Scholar] [CrossRef]
- Chelu, M.; Musuc, A.M. Polymer Gels: Classification and Recent Developments in Biomedical Applications. Gels 2023, 9, 161. [Google Scholar] [CrossRef]
- Miguel, S.P.; Ribeiro, M.P.; Coutinho, P.; Correia, I.J. Electrospun Polycaprolactone/Aloe Vera_Chitosan Nanofibrous Asymmetric Membranes Aimed for Wound Healing Applications. Polymers 2017, 9, 183. [Google Scholar] [CrossRef]
- International Agency for Research on Cancer. Aloe vera. In Some Drugs and Herbal Products (Volume 108); International Agency for research on Cancer: Lyon, France, 2015. Available online: http://monographs.iarc.fr/ENG/Monographs/vol108/mono108.pdf (accessed on 20 May 2023).
- Cosmetic Ingredient Review Expert Panel (CIR). Final report on the safety assessment of aloe andongensis extract, aloe an-dongensis leaf juice, aloe arborescens leaf extract, aloe arborescens leaf juice, aloe arborescens leaf protoplasts, aloe barbadensis flower extract, aloe barbadensis leaf, aloe barbadensis leaf extract, aloe barbadensis leaf juice, aloe barbadensis leaf polysac-charides, aloe barbadensis leaf water, aloe ferox leaf extract, aloe ferox leaf juice, and aloe ferox leaf juice extract. Int. J. Toxicol. 2007, 26 (Suppl. S2), 1–50. [Google Scholar]
- Boudreau, M.D.; Beland, F.A. An evaluation of the biological and toxicological properties of Aloe barbadensis (miller), Aloe vera. J. Environ. Sci. Health C Environ. Carcinog. Ecotoxicol. Rev. 2006, 24, 103–154. [Google Scholar] [CrossRef]
- Boudreau, M.D.; Beland, F.A.; Nichols, J.A.; Pogribna, M. Toxicology and carcinogenesis studies of a nondecolorized whole leaf extract of Aloe barbadensis Miller (Aloe vera) in F344/N rats and B6C3F1 mice (drinking water study). Natl. Toxicol. Program Tech. Rep. Ser. 2013, 577, 1–266. [Google Scholar]
- Guo, X.; Mei, N. Aloe vera: A review of toxicity and adverse clinical effects. J. Environ. Sci. Health Part C 2016, 34, 77–96. [Google Scholar] [CrossRef] [PubMed]
- Ryall, C.; Duarah, S.; Chen, S.; Yu, H.; Wen, J. Advancements in Skin Delivery of Natural Bioactive Products for Wound Management: A Brief Review of Two Decades. Pharmaceutics 2022, 14, 1072. [Google Scholar] [CrossRef] [PubMed]
- Ferreira, A.S.; Macedo, C.; Silva, A.M.; Delerue-Matos, C.; Costa, P.; Rodrigues, F. Natural Products for the Prevention and Treatment of Oral Mucositis—A Review. Int. J. Mol. Sci. 2022, 23, 4385. [Google Scholar] [CrossRef] [PubMed]

| Type | Compounds |
|---|---|
| Anthraquinones/anthrones | Aloe-emodin, aloetic-acid, anthranol, aloin A and B (collectively known as barbaloin) isobarbaloin, emodin, ester of cinnamic acid |
| Carbohydrates | Pure mannan, acetylated mannan, acetylated glucomannan, glucogalactomannan, galactan, pectic substance, arabinogalactan, galactoglucoarabinomannan, galactogalacturan, xylan, cellulose, acemannan |
| Enzymes | Alkaline phosphatase, amylase, carboxypeptidase, carboxylase, catalase, cyclooxidase, phosphoenolpyruvate, cyclooxygenase, superoxide dismutase, lipase, oxidase |
| Inorganic compounds | Calcium, chlorine, phosphorous, chromium, copper, magnesium, iron, manganese, potassium, sodium, zinc |
| Non-essential and essential amino acids | Alanine, arginine, aspartic acid, glutamic acid, glycine, histidine, hydroxyproline, isoleucine, leucine, lysine, methionine, proline, threonine, tyrosine, valine, phenylalanine |
| Proteins | Lectins, lectin-like substance |
| Saccharides | Mannose, glucose, L-rhamnose, aldopentose, |
| Vitamins | B1, B2, B6, C, β-carotene, choline, folic acid, α-tocopherol |
| Miscellaneous | Arachidonic acid, γ-linolenic acid, potassium sorbate, steroids (campesterol, cholesterol, β-sitosterol), triglycerides, triterpenoid, gibberellin, lignins, salicylic acid, uric acid |
| Enhanced Reported | References |
|---|---|
| Cell viability | Sholehvar et al. [115], Liu et al. [177] |
| Epitelial cell proliferation | Moriyama et al. [167], Hashemi et al. [170], Shanmugan et al. [178], Teplicki et al. [179] |
| Epitelial cell midration | Teplicki et al. [179], Negahdari et al. [180], Wahedi et al. [181], Muller et al. [182] |
| Moisture retention | Dal’Belo et al. [160], Hamman et al. [183] |
| Keratinocyte proliferation | Moriyama et al. [167] |
| Collagen quantity | Hekmatpou et al. [21], Rahman et al. [64], Nabipour et al. [121], Abdel Hamid et al. [169], Hashemi et al. [170], Shanmugan et al. [178] |
| Collagen cross-linking | Hekmatpou et al. [21], Rahman et al. [64], Abdel Hamid et al. [169], Shanmugan et al. [178] |
| GSH activity | Liu et al. [177] |
| SOD activity | Liu et al. [177] |
| Antioxidant enzyme activity | Anilakumar et al. [184], Hassanpour et al. [185] |
| Accelerated wound healing | Moriyama et al. [167], Maenthaisong et al. [171], Somboonwong et al. [173], Shanmugan et al. [178], Negahdari et al. [180], Wahedi et al. [178,179,180,181], Hormozi et al. [186], Ali et al. [187] |
| Growth factors production | Hashemi et al. [170], Wahedi et al. [181] |
| Wound closure | Curto et al. [188] |
| Lysosomal stabilization | Paul et al. [165], DeOliveira et al. [189] |
| Stimulate fibrotic cytokines | Wahedi et al. [181], Zeng et al. [190] |
| Angiogenesis | Moon et al. [175], Choi et al. [176] |
| Block the signaling of JAK1-STAT1/3 | Sánchez et al. [68] |
| Thromboxane reduction | Zeng et al. [21], Hekmatpou et al. [189] |
| Hindering IL-6 | Ma et al. [162], Jiang et al. [164] |
| Hindering IL-8 | Leng et al. [163], Na et al. [191] |
| Hindering IL-12 | Ahluwalia et al. [163], Leng et al. [166] |
| TNF alpha levels reduced | Leng et al. [163], Jiang et al. [164], Paul et al. [165], Ahluwalia et al. [166] |
| Erythema reduction | Fox et al. [174], Reuter et al. [192] |
| Pain reduction | Hekmatpou et al. [21], Rompicherla et al. [119] |
| T cell proliferation suppressed | Li et al. [193] |
| Lipid peroxidation reduced | Liu et al. [177] |
| Proinflammatory cytokines reduced | Ma et al. [162], Leng et al. [163], Jiang et al. [164], Paul et al. [165], Ahluwalia et al. [166] |
| Type IV collagen degradation | Curto et al. [188] |
| ROS production hindered | Ma et al. [162], Jiang et al. [164] |
| Inflammation reduction | Hekmatpou et al. [21], Paul et al. [165] |
Disclaimer/Publisher’s Note: The statements, opinions and data contained in all publications are solely those of the individual author(s) and contributor(s) and not of MDPI and/or the editor(s). MDPI and/or the editor(s) disclaim responsibility for any injury to people or property resulting from any ideas, methods, instructions or products referred to in the content. |
© 2023 by the authors. Licensee MDPI, Basel, Switzerland. This article is an open access article distributed under the terms and conditions of the Creative Commons Attribution (CC BY) license (https://creativecommons.org/licenses/by/4.0/).
Share and Cite
Chelu, M.; Musuc, A.M.; Popa, M.; Calderon Moreno, J. Aloe vera-Based Hydrogels for Wound Healing: Properties and Therapeutic Effects. Gels 2023, 9, 539. https://doi.org/10.3390/gels9070539
Chelu M, Musuc AM, Popa M, Calderon Moreno J. Aloe vera-Based Hydrogels for Wound Healing: Properties and Therapeutic Effects. Gels. 2023; 9(7):539. https://doi.org/10.3390/gels9070539
Chicago/Turabian StyleChelu, Mariana, Adina Magdalena Musuc, Monica Popa, and Jose Calderon Moreno. 2023. "Aloe vera-Based Hydrogels for Wound Healing: Properties and Therapeutic Effects" Gels 9, no. 7: 539. https://doi.org/10.3390/gels9070539
APA StyleChelu, M., Musuc, A. M., Popa, M., & Calderon Moreno, J. (2023). Aloe vera-Based Hydrogels for Wound Healing: Properties and Therapeutic Effects. Gels, 9(7), 539. https://doi.org/10.3390/gels9070539








